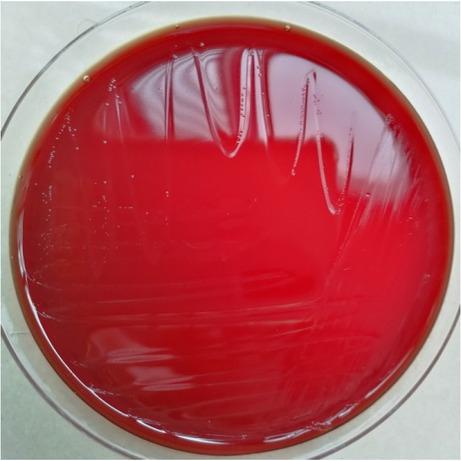
Culture of the pure E. lenta isolate after 72 h.

Fig.1
Fig. 2

Fig. 3

Fig. 4

Antibiotic sensitivity of E_ lenta isolates_
| Antibiotics | MIC (mg/l) | Results |
|---|---|---|
| Piperacillin-tazobactam | 16 | Sensitive |
| Imipenem | 0.5 | Sensitive |
| Meropenem | 0.5 | Sensitive |
| Metronidazole | 0.5 | Sensitive |
| Clindamycin hydrochloride | 1 | Sensitive |
| Vancomycin | 2 | Sensitive |
| Amoxicillin | 16 | Resistant |
| Penicillin | 16 | Resistant |
| Cefotaxime | 64 | Resistant |
| Ceftriaxone | 64 | Resistant |